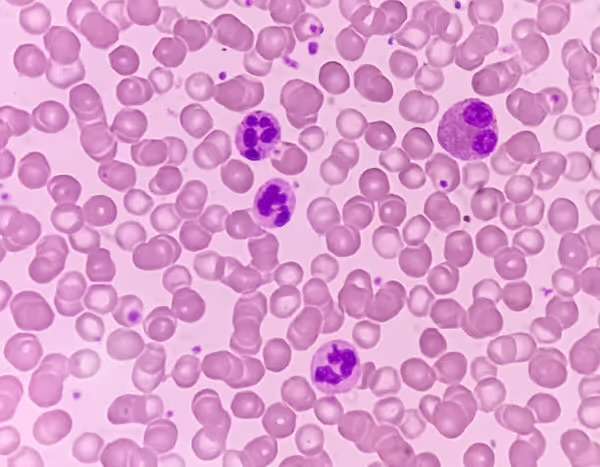
Neutropenia

Publicado enGinecología
¿Son efectivas las vacunas contra todos los tipos de VPH?
La razón fundamental por la cual las vacunas contra el Virus del Papiloma Humano no ofrecen una protección completa frente a todos los tipos carcinógenos radica en la compleja diversidad…